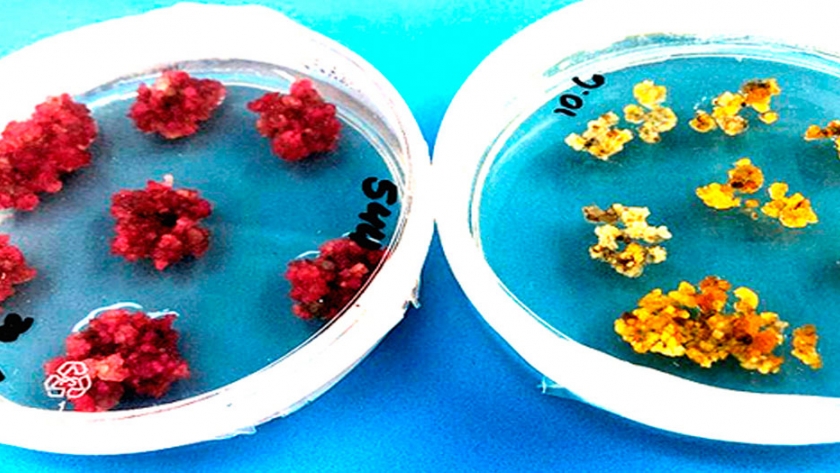
Desarrollan algodón genéticamente modificado de colores, eliminando la necesidad de colorantes sintéticos

speran que esto elimine la necesidad de colorantes químicos que pueden ser perjudiciales para el medio ambiente. Además, los científicos también pretenden crear un algodón elástico y que no se arruga para reemplazar las telas sintéticas.
Un par de docenas de placas de Petri en un invernadero de alta tecnología en Canberra, Australia, tienen el potencial de transformar la industria textil global.
Contienen tejido vegetal que en cuestión de días se convertirá en plantas de algodón: no de color blanco, el algodón blanco cotidiano, sino en una deslumbrante variedad de colores.
Son el producto del trabajo de los mejoradores de plantas de Organización de Investigación Científica e Industrial del Commonwealth (CSIRO), una entidad pública-federal australiana, dedicados a producir fibras naturales mejores y sostenibles que, con suerte, algún día conducirán a un algodón elástico sin arrugas, teñido naturalmente y elástico para superar a las telas sintéticas.
Colleen MacMillan lidera el equipo de científicos que descifró el código de color molecular del algodón y agregó genes para que las plantas produzcan un color. “Hacer que el algodón produzca su propio color es un cambio de juego”, dijo el Dr. MacMillan.
“Hemos visto algunos amarillos brillantes realmente hermosos, una especie de colores naranja-dorado, hasta un color morado muy intenso”, dijo la compañera científica Filomena Pettolino.
Pasarán varios meses antes de que el colorido tejido vegetal que han creado se convierta en plantas de algodón con flor; solo entonces los científicos estarán absolutamente seguros de su éxito.
Pero todo apunta de esa manera.
Otro signo positivo es que los genes de algodón coloreados, insertados en plantas de tabaco verdes, se han mostrado como manchas de colores en las hojas. Si las hojas del algodón biotecnológico (genéticamente modificado) son de color, la fibra más importante también lo será.
Para los científicos involucrados, el descubrimiento fue un momento eureka. “Cuando vimos los resultados, se me llenaron los ojos de lágrimas porque fue un momento muy especial”, dijo el Dr. MacMillan.
“No creíamos que sucedería”.
La industria algodonera de Australia, con un valor aproximado de AUD$2 mil millones anuales, será un gran beneficiario.
Si bien el algodón es renovable, reciclable y biodegradable, aún debe teñirse, y el uso de tintes químicos a veces nocivos se considera una mancha en el cuaderno ambiental de la industria.
Particularmente significativo es el trabajo del equipo de CSIRO para desarrollar algodón negro natural para reemplazar los tintes negros, que se consideran los colores textiles más contaminantes.
El director ejecutivo de Cotton Australia, Adam Kay, observa de cerca el trabajo de los científicos.
“Hemos hecho todas estas cosas para mejorar nuestras credenciales ambientales, pero aún así el uso de tintes es algo que puede tener un impacto en el medio ambiente”, dijo Kay.
Se estima que, en promedio, cada australiano produce alrededor de 25 kilogramos de residuos textiles cada año. Gran parte es sintética y termina en vertederos, donde tardará cientos de años en degradarse.
La Dra. MacMillan dijo que había una creciente conciencia del costo ambiental de la moda rápida.
“Esta [investigación] realmente puede tener el potencial de transformar la industria textil mundial, porque estamos fabricando fibras que, aunque son biodegradables, renovables, pero que aún tienen propiedades que actualmente no tienen”, dijo. “Eso es un gran problema para la sostenibilidad”.
La Dra. Pettolino dijo que alejarse de los materiales sintéticos en favor del algodón sería un paso importante para proteger el medio ambiente.
“Las microfibras sintéticas terminan en el medio ambiente y pueden hacer más daño que el plástico normal, por lo que es importante que nos alejemos de eso para proteger el medio ambiente”, dijo.
El equipo también está trabajando en un proyecto a largo plazo, creando algodón que no se arruga y que no requiere planchado.
Esto significa seleccionar y testear miles de plantas de algodón para transformarlas en nuevas variedades de súper-algodón para producir fibra con mayor elasticidad que pueda competir con las sintéticas.
La diseñadora de lencería de Sydney, Stephanie Devine, acoge con beneplácito el trabajo de variedades de algodón para reemplazar los sintéticos.
Cuando se enteró de que la industria textil era la segunda más contaminante del mundo, organizó una campaña de crowdfunding para producir el primer sujetador compostable que es fuerte y elástico pero que no usa materiales sintéticos.
Ella dijo que esto era un enorme desafío. “He estado buscando material de todo el mundo”, dijo Devine.
“Tuve que encontrar el caucho de árbol, un algodón orgánico [que es] elástico, por lo que tiene buena elasticidad, pero también puede ser comido por gusanos o compostado”.
A pesar del desafío de asegurar materiales biodegradables, ella ha podido hacer ropa interior para la “economía circular” que puede biodegradarse. También espera que el trabajo de CSIRO produzca un cambio más amplio en la industria.
“En promedio, el 60% de nuestra ropa está hecha de poliéster, que dura 200 años en los vertederos, y generalmente solo usamos fibras naturales en el 6% de nuestra ropa “, dijo.
“Hay un desequilibrio real allí, y creo que estamos empezando a cambiar eso, pero las fibras naturales, el algodón, la lana, tencel, son realmente la forma en que debemos ir como industria”.
Pregon Agropecuario
